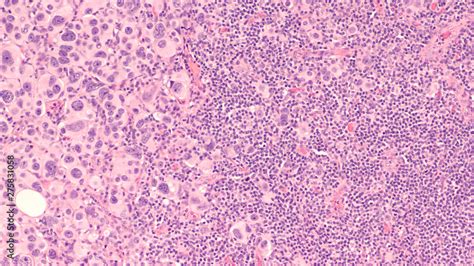

ICD-10 Code: Breast Cancer Metastasis To Left Axillary Lymph Node
ICD-10 Code: Breast Cancer Metastasis to Left Axillary Lymph Node
Hey there, healthcare enthusiasts! Let’s dive into the nitty-gritty of ICD-10 codes , specifically when dealing with the tricky situation of breast cancer metastasis to the left axillary lymph node . This is super important for accurate medical documentation, billing, and, ultimately, providing the best care possible. So, grab your coffee, and let’s break it down in a way that’s both informative and easy to digest. We’ll be covering the crucial ICD-10 codes , the nuances of this specific type of cancer spread, and why getting it right matters big time. Whether you’re a seasoned coder, a healthcare professional, or just someone curious about medical terminology, this guide is for you. Ready to unravel the complexities? Let’s go!
Table of Contents
Understanding Breast Cancer Metastasis
First things first, what exactly does breast cancer metastasis to the axillary lymph nodes mean? Basically, it’s when cancer cells from the breast travel and spread to the lymph nodes located in the armpit (the axillary region). These lymph nodes are part of your body’s lymphatic system, which helps fight off infections and diseases. When cancer cells invade these nodes, it signifies that the cancer has spread beyond the original tumor site. The axillary lymph nodes , on the left side in this case, act as a primary drainage area for the left breast. So, if cancer cells break away from the original tumor, they often make their way to these nodes first. This spread is a crucial factor in staging the cancer and determining the best course of treatment. This is not a good situation, guys. That’s why it is critical for correct and prompt diagnosis and treatment. This is where those ICD-10 codes come in, playing a vital role in capturing the complete picture of a patient’s condition.
The spread of breast cancer to the lymph nodes can occur through the lymphatic system. Lymphatic vessels are like tiny pipelines that carry lymph fluid, which contains immune cells, throughout the body. Cancer cells can enter these vessels and travel to nearby lymph nodes. Once in the lymph node, the cancer cells can start to grow and form new tumors, leading to metastasis . The presence of cancer in the lymph nodes is a significant prognostic factor, which means it helps doctors predict how the cancer will behave and the likelihood of its spread to other parts of the body. If the cancer has spread to the lymph nodes, it is usually a sign that it is at a more advanced stage. The more nodes that are affected, the more advanced the cancer is considered to be. The size and number of the affected lymph nodes will significantly affect the prognosis and the treatment plan. It is necessary to correctly determine the stage of the cancer to determine the treatment and prognosis correctly.
Why the Left Side Matters
When we specifically talk about the left axillary lymph nodes , there are a couple of things to keep in mind. Due to the anatomical position, the left side has a particular importance because it’s closer to certain vital structures like the heart and lungs. While the general principles of metastasis apply to both sides, the involvement of the left side might require a slightly different approach in treatment planning, especially when it comes to radiation therapy. The proximity of the heart means that doctors must be extremely careful when delivering radiation. Accurately documenting this in the patient’s records is necessary for a focused and effective approach. This is why the correct ICD-10 code is so crucial. It’s not just about numbers and labels; it is about providing the best care possible. Also, the involvement of the left side is also an important factor in the overall staging of the disease. This will include the overall treatment plan and overall outcome of the patient. Guys, you do not want to take anything lightly when dealing with cancer. The more information and details doctors can gather, the better the treatment plan is.
Decoding ICD-10 Codes: The Basics
Alright, let’s get into the heart of the matter: ICD-10 codes . These are the standardized codes used worldwide to classify and report diseases, signs, symptoms, abnormal findings, injuries, and external causes of injury or disease. Think of them as a universal language for healthcare professionals. They ensure everyone is on the same page when documenting and sharing information about a patient’s condition. The World Health Organization (WHO) maintains the ICD-10 system , and it is regularly updated to reflect the latest medical knowledge and advancements. In the United States, the Centers for Disease Control and Prevention (CDC) and the Centers for Medicare & Medicaid Services (CMS) oversee the use of ICD-10 codes for billing and statistical purposes. The codes are crucial for tracking disease trends, supporting research, and ensuring that healthcare providers are appropriately reimbursed for the services they provide. You might be wondering, why are these codes so important? Well, they provide a structured way to document and track diseases, which is essential for things like epidemiological studies, public health initiatives, and clinical trials. They are also used for billing purposes. Healthcare providers use the appropriate codes to bill insurance companies for the services they provide. This includes everything from doctor’s visits to hospital stays, tests, and treatments. Accurate coding ensures that providers are paid appropriately for their services. Additionally, they are used to analyze healthcare data. Researchers and policymakers use ICD-10 codes to analyze healthcare data, identify trends, and develop strategies to improve healthcare outcomes. This is a very complex process. So, it is important to accurately diagnose and document everything. This will ensure that everything is on the same page.
How ICD-10 Codes Work
Each ICD-10 code is alphanumeric, consisting of three to seven characters. The first character is always a letter, and the following characters are numbers or letters. The code’s structure is hierarchical, meaning that it goes from broad categories to more specific details. The first three characters of a code represent the category, which describes the general nature of the condition. For example, codes starting with